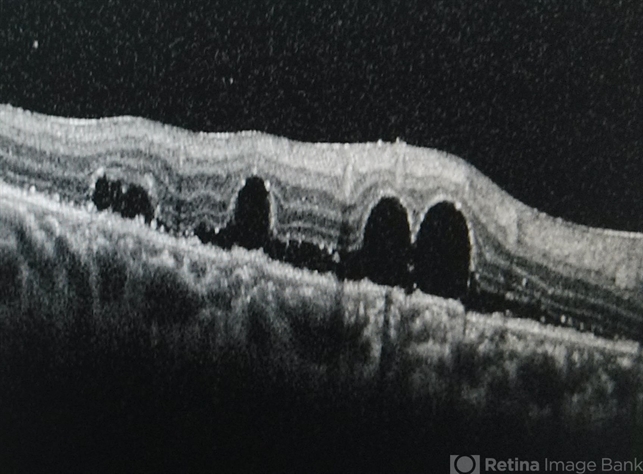

-
 By Jinfeng Qu
By Jinfeng Qu
Peking University People's Hospital - Uploaded on Aug 20, 2014.
- Last modified by Caroline Bozell on Aug 21, 2014.
- Rating
- Appears in
- Miscellaneous
- Condition/keywords
- perfluorooctane
- Description
- Perfluorooctane drops under the retina.

Initializing download.
Initializing download.

